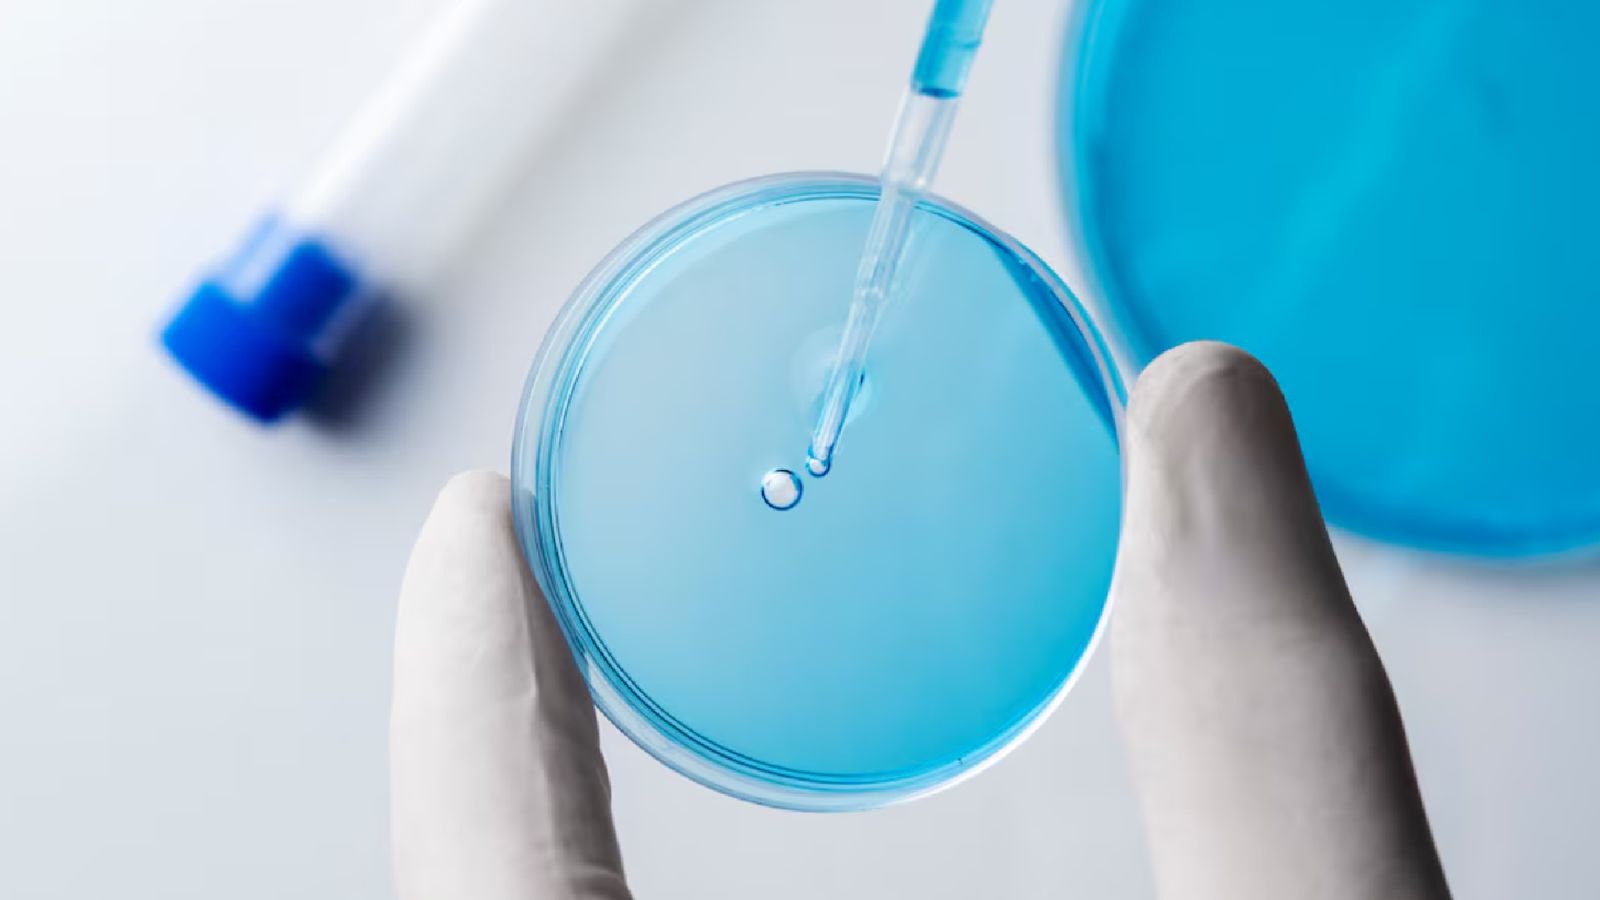

Publicaciones
Professional Line


Derma Signal Kit SRLV
Exosomas Exocobio® con factores de crecimiento, péptidos, vitaminas y glutatión que regeneran, iluminan e hidratan la piel.

Scalp Care HRLV
Exosomas de células madre de rosa con factores y nutrientes que fortalecen y revitalizan el cabello.

ASCEplus IRLV
Tratamiento profesional para mejorar elasticidad, hidratación y confort íntimo femenino mediante exosomas de rosa damascena y factores regenerativos.
Home Care


Soothing Gel Mask
Exosomas activos RSC-Exosome (ExoCoBio) con péptidos y Centella Asiática que hidratan, reparan y calman la piel.

Sunshine Cushion Pro
Protector solar con exosomas ExoCoBio FPS 50+ que calma, hidrata y refuerza la piel con péptidos y ceramidas.

Firming Moisturizer Pro
Exosomas ExoCoBio con colágeno y péptidos que hidratan, dan firmeza y reducen arrugas.

Calming Ampoule Pro
Exosomas ExoCoBio con péptidos y pantenol que calman, hidratan y fortalecen la piel sensible.

Exobalm Kit
Exosomas ASCE que regeneran, calman e iluminan la piel, acelerando su recuperación y prolongando los resultados.

Estudios y
evidencia
Cada desarrollo de ExoCoBio se apoya en investigaciones publicadas y ensayos clínicos que demuestran su capacidad para regenerar, reparar y mejorar la piel a nivel celular, con resultados visibles y medibles.
Resultados Comprobados


Karina – 50 años
- Reducción de arrugas periorbitales.
- Fotos: Dr. Richard Jin (USA)
- Protocolo: Aplicado después del tratamiento con radiofrecuencia fraccionada.

- Mejora de cantidad y calidad capilar en alopecia androgénica.
- Fotos: Dr. Ali Amari (Francia)
- Protocolo: 6 sesiones (cada 2 semanas).

- Quemadura inducida por radiación con hemorragia, ampollas y dolor.
- Fotos: Diane Duncan MD. FACS (USA)
- Protocolo: 2 tratamientos al día durante 1 semana.

Carlos – 37 años
- Mejora de cantidad y calidad capilar en alopecia androgénica.
- Fotos: Dr. Ali Amari (Francia)
- Protocolo: 6 sesiones (cada 2 semanas).

- Repigmentación capilar en poliosis circunscripta con alopecia androgénica
- Fotos: Dr. Suparuj Lueangarun (Tailandia)
- Protocolo: 4 sesiones (1 cada 4 semanas, sin otros tratamientos).

Líder global en exosomas
La biotecnología más avanzada del mundo llega a la estética: exosomas de alta pureza capaces de reactivar la regeneración celular, acelerar la reparación cutánea y devolverle a tu piel su vitalidad natural.
en innovación
en innovación
ExoCoBio


1
Aislamiento y purificación
Contamos con tecnología de aislamiento y purificación capaz de obtener exosomas del 0,1 al 0,5 % a partir de medios condicionados de células madre.
2
Producción eficiente
Poseemos una tecnología patentada para la producción masiva de exosomas altamente eficientes, adecuados para el desarrollo biomédico.
3
Medicina regenerativa
Hemos desarrollado una tecnología patentada optimizada para la medicina regenerativa.

Funciones clave del ExoSCRT Exosome
Como componente clave del efecto paracrino de las células madre, regula la regeneración y la inmunidad de las células circundantes dañadas.
Regeneración
Antiinflamatorio
Modulación inmunológica
Absorción celular
Seguridad

Sobre la tecnología ExoSCRT™

ExoSCRT™ es una tecnología patentada desarrollada por ExoCoBio para obtener exosomas altamente puros y eficientes a gran escala. Su diseño garantiza una alta reproducibilidad y permite la producción masiva sin comprometer la calidad biológica de las vesículas.
A diferencia de técnicas convencionales, ExoSCRT™ logra separar exosomas con precisión, minimizando impurezas y maximizando su integridad funcional, lo que se traduce en mejores resultados terapéuticos y cosméticos.
Cada exosoma ExoSCRT™ contiene aproximadamente 40 000 lípidos, 610 microARN y 1 000 proteínas, todos esenciales para la comunicación y regeneración celular.
Incluye 96 miARN y 200 proteínas directamente vinculados con la regeneración cutánea, ayudando a reparar tejidos y restaurar la función celular.
Contienen 56 miARN con funciones antiinflamatorias y de mantenimiento de la barrera cutánea, además de propiedades antienvejecimiento, blanqueadoras y reguladoras de la proliferación celular.
Los exosomas ExoSCRT™ poseen 45 miARN que suprimen citocinas inflamatorias responsables de la picazón y la dermatitis atópica, ayudando a calmar la piel y reducir la irritación.
Los lípidos han demostrado su eficacia en la reconstrucción y fortalecimiento de la barrera cutánea, protegiendo la piel frente a agresores externos y pérdida de humedad.
Su eficiencia se debe a que comparten la misma membrana lipídica que las células humanas, lo que facilita la absorción y comunicación intercelular de manera natural y biocompatible.

Suscríbete hoy
Recibe noticias sobre innovación biotecnológica, avances en salud y actualizaciones exclusivas directamente en tu correo o WhatsApp.

ExoCoBio cuenta con distribución oficial en Chile a través de Pronaturae Asesorías e Inversiones Spa, empresa dedicada a introducir soluciones biotecnológicas innovadoras para el cuidado y regeneración de la piel.
Contáctanos
- Pronaturae SPA
- Puerta Oriente 361, Of. 601 Torre C. Centro
- +56 9 3081 9106
- +56 9 3012 0343